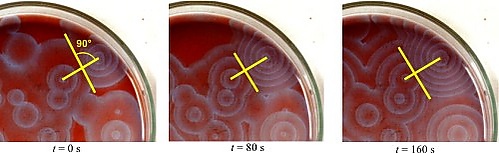

Реакция Белоусова — Жаботинского
Реакция Белоусова — Жаботинского — класс химических реакций, протекающих в колебательном режиме, при котором некоторые параметры реакции (цвет, концентрация компонентов, температура и др.) изменяются периодически, образуя сложную пространственно-временную структуру реакционной среды.
В настоящее время под этим названием объединяется целый класс родственных химических систем, близких по механизму, но различающихся используемыми катализаторами (Ce3+, Mn2+ и комплексы Fe2+, Ru2+), органическими восстановителями (малоновая кислота, броммалоновая кислота, лимонная кислота, яблочная кислота и др.) и окислителями (броматы, иодаты и др.).
При определенных условиях эти системы могут демонстрировать очень сложные формы поведения от регулярных периодических до хаотических колебаний и являются важным объектом исследования универсальных закономерностей нелинейных систем. В частности, именно в реакции Белоусова — Жаботинского наблюдался первый экспериментальный странный аттрактор в химических системах и была осуществлена экспериментальная проверка его теоретически предсказанных свойств.
История открытия колебательной реакции Б. П. Белоусовым, экспериментальное исследование её и многочисленных аналогов, изучение механизма, математическое моделирование, историческое значение приведены в коллективной монографии[1].
История открытия
Борис Павлович Белоусов проводил исследования цикла Кребса, пытаясь найти его неорганический аналог. В результате одного из экспериментов в 1951 году, а именно окисления лимонной кислоты броматом калия в кислотной среде в присутствии катализатора — ионов церия Ce+3, он обнаружил автоколебания. Течение реакции менялось со временем, что проявлялось периодическим изменением цвета раствора от бесцветного (Ce+3) к жёлтому (Ce+4) и обратно. Эффект ещё более заметен в присутствии индикатора ферроина. Сообщение Белоусова об открытии было встречено в советских научных кругах скептически, поскольку считалось, что автоколебания в химических системах невозможны. Статью Белоусова[2] дважды отклоняли в редакциях советских журналов, поэтому опубликовать результаты исследований колебательной реакции он смог только в сокращённом виде спустя 8 лет в ведомственном сборнике, выходившем небольшим тиражом[3]. Впоследствии эта статья стала одной из самых цитируемых в данной области, а реакция получила название реакции Белоусова.
Дальнейшее развитие исследований этой реакции произошло, когда профессор Симон Эльевич Шноль предложил своему аспиранту, в будущем лауреату Ленинской премии Анатолию Марковичу Жаботинскому исследовать механизм реакции. От приглашения проводить совместные исследования Белоусов отказался, хотя выражал удовлетворение тем, что его работа продолжена[4]. Жаботинский провёл подробные исследования реакции, включая её различные варианты, а также составил её первую математическую модель (1964)[5]. Основные результаты были изложены в книге Жаботинского «Концентрационные колебания»[6][7].
В 1969 году Жаботинский с коллегами обнаружили, что если реагирующую смесь разместить тонким плоским слоем, в нём возникают волны изменения концентрации, которые видны невооружённым глазом в присутствии индикаторов.
Сейчас известно довольно много реакций типа Белоусова — Жаботинского, например, реакция Бриггса — Раушера.
Механизм реакции
Жаботинский предложил первое объяснение механизма реакции и простую математическую модель, которая была способна демонстрировать колебательное поведение. В дальнейшем описание механизма было расширено и уточнено, экспериментально наблюдаемые динамические режимы, включая хаотические, были теоретически рассчитаны, и показано их соответствие эксперименту. Полный список элементарных стадий реакции очень сложен и составляет почти сотню реакций с десятками веществ и интермедиатов. До сих пор подробный механизм неизвестен, особенно константы скоростей реакций.
Первая модель реакции Белоусова — Жаботинского была получена в 1967 году Жаботинским и Корзухиным на основе подбора эмпирических соотношений, правильно описывающих колебания в системе[8]. В её основе лежала знаменитая консервативная модель Лотки — Вольтерры.
здесь = [Ce4+], C=[Ce4+]0 + [Ce3+]0, — концентрация автокатализатора, = [Br−].
Простейшая модель, предложенная Пригожиным[9], которая имеет колебательную динамику.
| I | A | → | X | |
| II | B + X | → | Y + D | |
| III | 2X + Y | → | 3X | (автокатализ) |
| IV | X | → | E | |
| V | A + B | → | E + D | |
Механизм, предложенный Филдом и Нойесом[10], является одним из простейших и в то же время наиболее популярным в работах, исследующих поведение реакции Белоусова — Жаботинского:
| I | A + Y | X | ||
| II | X + Y | P | ||
| III | B + X | 2 X + Z | ||
| IV | 2 X | Q | ||
| V | Z | f Y |
Соответствующая система обыкновенных дифференциальных уравнений:
Эта модель демонстрирует простейшие колебания, похожие на экспериментально наблюдаемые, однако она не способна показывать более сложные типы колебаний, например сложнопериодические и хаотические.
Модель Шоуалтера, Нойеса и Бар-Эли[11] разрабатывалась для моделирования сложнопериодического и хаотического поведения реакции. Однако хаос получить в этой модели не удалось.
| 1 | A + Y | X + P | ||
| 2 | X + Y | 2 P | ||
| 3 | A + X | 2 W | ||
| 4 | C + W | X + Z' | ||
| 5 | 2 X | A + P | ||
| 6 | Z' | g Y + C |
где — BrO3−; — HBrO2; — Br−; — Ce3+; ' — Ce4+; — BrO2•; — HOBr.
Наиболее полный известный реакционный механизм[12] представляет собой набор 80 элементарных реакций.
Значение открытия реакции
Реакция Белоусова — Жаботинского стала одной из самых известных в науке химических реакций, её исследованиями занимаются множество учёных и групп различных научных дисциплин и направлений во всём мире: математике, химии, физике, биологии. Обнаружены её многочисленные аналоги в разных химических системах (см., например, твердофазный аналог — органический самораспространяющийся высокотемпературный синтез). Опубликованы тысячи статей и книг, защищено множество кандидатских и докторских диссертаций. Открытие реакции фактически дало толчок к развитию таких разделов современной науки, как синергетика, теория динамических систем и детерминированного хаоса.
Учитывая значимость выявленных реакций для науки, эта работа была признана как научное открытие и занесена в Государственный реестр открытий СССР под № 174[13].
См. также
Примечания
Ссылки
- Из истории открытия и изучения автоколебательных процессов в химических системах: к 50-летию открытия реакции Белоусова — Жаботинского
- Б. П. Белоусов и его колебательная реакция, журнал «Знание — сила»
- Реакционные схемы Белоусова Жаботинского и Бриггса Раушера Архивная копия от 4 апреля 2008 на Wayback Machine, дифференциальные уравнения
- The Phenomenology of the Belousov-Zhabotinsky Reaction
- В. А. Вавилин. Автоколебания в жидкофазных химических системах
- А. А. Печенкин. Мировоззренческое значение колебательных химических реакций (недоступная ссылка)
- Belousov-Zhabotinsky reaction (a Scholarpedia article)
- Колебания и бегущие волны в химических системах. / Р. Филд, М. Бургер.. — М.: Мир, 1988.

![{\displaystyle {\frac {d[X]}{dt}}=k_{I}[A][Y]-k_{II}[X][Y]+k_{III}[B][X]-k_{IV}[X]^{2}}](https://ru.ruwiki.ru/api/rest_v1/media/math/render/svg/27d3e7456c880a854397b1660d6fe63808c4c802)
![{\displaystyle {\frac {d[Y]}{dt}}=-k_{I}[A][Y]-k_{II}[X][Y]+fk_{V}[Z]}](https://ru.ruwiki.ru/api/rest_v1/media/math/render/svg/64deaae2861919563024d552a51e01d8858e1437)
![{\displaystyle {\frac {d[Z]}{dt}}=k_{III}[B][X]-k_{V}[Z]}](https://ru.ruwiki.ru/api/rest_v1/media/math/render/svg/f4c6a743017b43b920cc3bbe09757b3f11e9e3e8)











